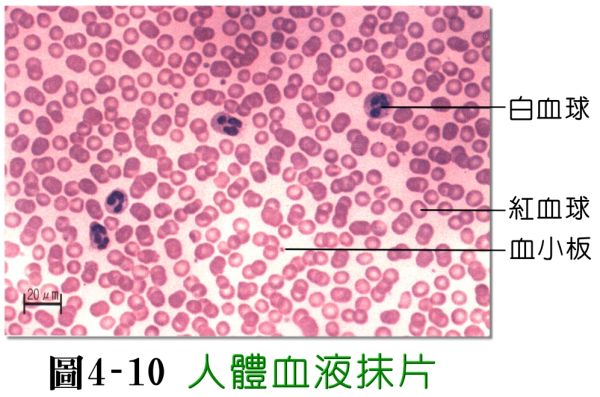

請選擇您想搜尋的行業別項目
全部搜尋結果共找到 596家企業
◎承接各醫療單位*健保*檢驗、X光處方籤◎ ◎員工體檢◎食品餐飲人員體檢◎健檢套組服務◎血液、尿液、糞便、肝腎功能◎糖尿病、胰臟◎全身健康檢查◎婚前健檢◎公司...
網址: http://www.minsheng.url.tw/
服務項目: RT-PCR,X光檢查,rt pcr,食物過敏,環境過敏

台北上群動物醫院給寵物們最好的醫療照顧、寵物保健、傳染病預防,寵物心臟病,寵物手術治療,動物外科,骨科。...
網址: http://www.shangshun.com.tw
服務項目: 動物醫院,寵物醫院,動物外科

台灣醫學檢驗的第一品牌保吉企業所設立-健康吉美體系於1999年開始跨入健康檢查領域,客制化的健檢服務,提供個人化的全身健康檢查管理服務,依據國人生活習慣、健康狀...
網址: http://www.handb.com.tw
服務項目: 健康檢查,健檢,健檢中心

易購王(網)成立於2007年,位於美國。我们深信~擁有健康,才能打造最完美的生活,我們提供最專業的代買及團購服務,讓您無論身在何時何地,都能享受到安心、便捷、優...
網址: http://www.togowant.com/
服務項目: 易購王(網)代買美國 維他命萊萃美、瘦身用品、DHEA

~忙了一整天 抽個空 給自己心裡沉澱吧~
疲憊已久的身心 想要解壓及放鬆嗎?
#########################
獨特細膩手法、全面...
網址: http://tw.myblog.yahoo.com/ac0728g
服務項目: ~忙了一整天 抽個空 給自己心裡沉澱吧~

安徽原廠三體牛鞭丸,保證100%原廠出品,純中藥製成.
為遵重您的隱私 保密取貨 保密送貨 貨物包裝隱秘
...
網址: http://tw.myblog.yahoo.com/yumen-go
服務項目: 房中之寶 延長性時間 挺而有力

集合植牙,牙齒矯正,近視雷射,婦產科,醫學美容,月子中心,皮膚科等各科醫學資訊及診所資訊,提供各診所服務項目,位置地點,相關消息等。...
網址: http://medical.freepage.com.tw
服務項目:

健康空氣的完美解決方案,世界第一品牌推薦,加濕器AIR-O-SWISS與空氣清淨機IQAir,空氣濾淨器,空氣清淨機,空氣清淨器,多種功能提供最有效且全方位的空...
網址: http://www.aplus-tw.com/
服務項目: 空氣清淨機

光流牙醫診所提供人工植牙,牙齒矯正,全瓷牙冠假牙等診療,醫師在植牙過程的細心與專業,使患者術後快速恢復,雖然水雷射植牙的療程與費用較傳統假牙來得長與貴,但以長遠...
網址: http://www.icreateteeth.com.tw/

提供快速齒顎矯正,牙齒矯正,牙齒美白,專門打造完美齒列及臉型,讓牙醫界的精英團隊來幫助你改善暴牙,咬合不正等問題,本診所使用高科技矯正器,幫助你的牙齒重新恢復燦...
網址: http://dentist.freepage.com.tw/
服務項目: 牙齒矯正,牙齒美白